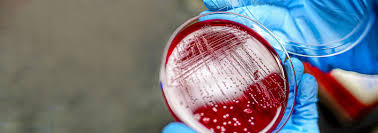

ABOUT CONFERENCE
ORGANIZING COMMITTEE
Speakers
CALL FOR ABSTRACTS
REGISTRATION
Venue Details
E-Poster Submission
Young Research Forum
Sponcership
Guidelines & Policies
Terms & Conditions
Support
About the Conference
The World Congress on Microbial Sciences & Innovations 2026 (WCMSI 2026) brings together leading microbiologists, clinicians, researchers, industry partners, and policy makers to discuss ground breaking research, modern trends, and global challenges in microbial science.
Hosted in Dubai, a global hub for innovation and scientific exchange, the event provides a dynamic platform to explore advancements in clinical microbiology, microbial biotechnology, infectious diseases, genomics, AMR, environmental microbiology, industrial applications, and more.
This two-day congress features expert-led keynote sessions, interactive workshops, panel discussions, poster presentations, and networking opportunities that foster international collaboration and knowledge exchange.
Conference Highlights
- World-Renowned Speakers
- Scientific Sessions Across all Major Microbiology Disciplines
- Cutting-Edge Research Presentations & Case Studies
- Workshops on Genomics, AMR, AI in Microbiology & Bioinformatics
- Industry Exhibition: Diagnostics, Biotech, Therapeutics & Laboratory Innovations
- Young Researcher Forum & Best Presentation Awards
- Networking Sessions with Global Microbial Science Leaders
Important Notes
|
Early Bird Registration:
May 19th, 2026 |
|
Mid Term Registration:
July 19th, 2026 |
|
Late Registration:
September 9th, 2026 |
|
Abstract Submission:
August 15, 2026 |
|
Acceptance Notification:
October 10, 2026 |
|
Full Paper Submission (optional):
October 20, 2026 |
|
Early-Bird Registration Deadline:
July 15, 2026 |
|
For Discounts and more details on Registration
Contact us: info@orcmeetings.org |
ORGANIZING COMMITTEE
No Committe Found!
Speakers
No Speakers Found!
CALL FOR ABSTRACTS
POSTER SUBMISSION
Venue & Hospitality
E-Poster Submission
Young Research Forum
Sponcorship Guide
Guidelines & Policies
Terms & Conditions
Scientific Program
Speakers
SCIENTIFIC SESSIONS
WHY CHOOSE US
CONFERENCE AGENDA
Media Partners and Collaborations
Registration
Speaker Registration
$ 799
- Access to Main Conference Sessions, Exhibits, Poster Sessions and Round Table Discussions
- Handbook & Conference Kit
- Tea / Coffee Breaks, Lunch During the Conference Days
- Certificate of Presentation
Delegate Registration
$ 999
- Access to Main Conference Sessions, Exhibits, Poster Sessions and Round Table Discussions
- Handbook & Conference Kit
- Tea / Coffee Breaks, Lunch During the Conference Days
- Certificate of Presentation
Student Registration
$ 599
- Access to Main Conference Sessions, Exhibits, Poster Sessions and Round Table Discussions
- Handbook & Conference Kit
- Tea / Coffee Breaks, Lunch During the Conference Days
- Certificate of Presentation